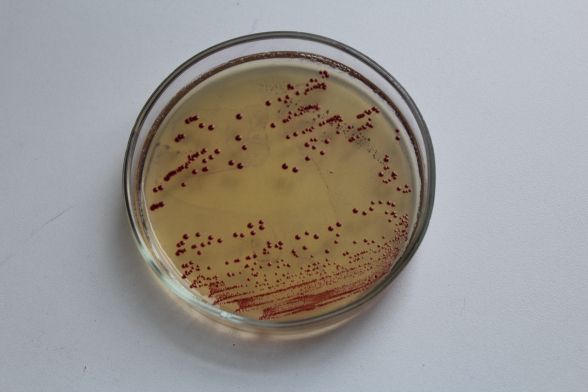
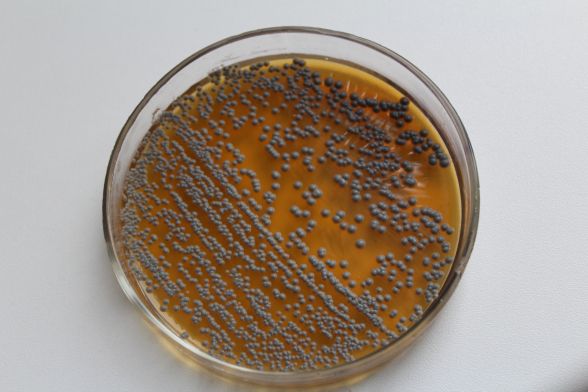
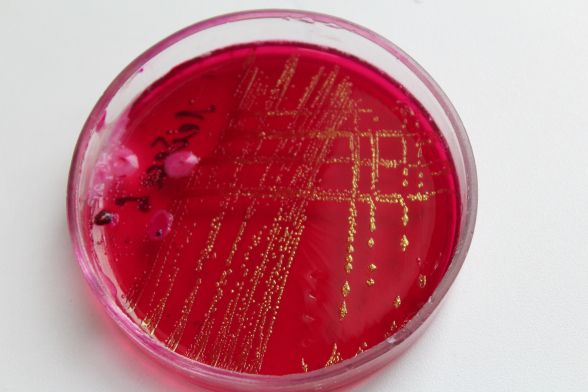
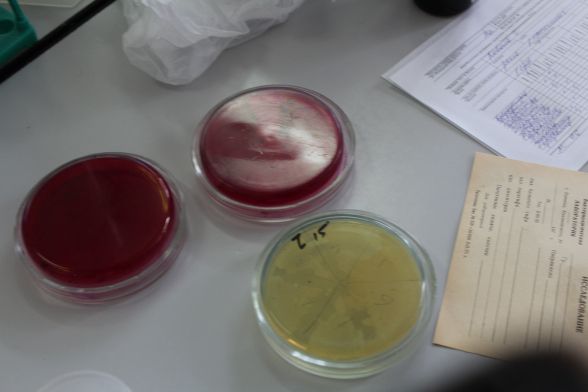

На ваших гривнях є кишкова паличка і стафілокок. Журналісти це перевірили

Фраза "брудні гроші" має і переносне, і пряме значення. Одна купюра за своє "життя" буває в руках сотні тисяч людей. Тож бруд на грошах - природне явище, а от які мікроби, то цікаво
Перевірити “якість” бруду на грошах ми вирішили після перевірки на нітрати ранніх овочів та фруктів, про які писали в минулому номері газети RIA та на сайті 20minut.ua. Овочі ми не кожен день купуємо, а з грошима ж маємо справу повсякденно. Стало цікаво, що саме проходить через наші руки.
Знову звернулися по допомогу до Донецького університету в хімічну лабораторію, але там таких аналізів не роблять, тому зателефонували директору обласного лабораторного центру санепідемстанції Валентині Зайцевій.
- Гроші перевірити? - засміялась директорка. - Можна і без аналізів сказати, що вони брудні, не дарма так про них кажуть. Хоча мені теж цікаво, що там на них мешкає. Приносьте, які у вас там купюри, перевіримо.
Купюр було не густо, лише одна номіналом 100 грн, одна гривнева, та копійки.
- А нічого, тут у наших зберемо, - сказала лікар і додала. - Чекаю.
У баклабораторії
Завідувачка баклабораторії, бактеріолог Олена Марцінковська спочатку не зрозуміла, в чому сенс такої перевірки, адже зрозуміло, що гроші брудні, мовляв, чого шукати. Але потім згодилася.
- Добре, перевіримо їх на патогенні мікроби, які можуть викликати захворювання, - сказала Олена Марцінковська і принесла в лабораторію купюри різного номіналу.
Зовсім весь “спектр” від одної гривні до 500 грн знайти не вдалося.
На перевірку взяли шість зразків - одна гривня, 10 гривень, 20 гривень, 100 гривень, 500 гривень і 50 копійок.
Лаборант взяла шість герметично запакованих пробірок, стерильним тампоном зробила змиви з кожної купюри. Зразки пронумерували і на три дні помістили до спеціальної печі, щоб накопичити мікроби і мати можливість їх висіяти.
Чистих грошей не буває
За результатами аналізів маємо: на купюрах номіналом одна гривня, 10 гривень та 20 гривень в лабораторії висіяли кишкову паличку. На 10гривневій купюрі, крім того ще й знайшли стафілокок, втім, його висіяли і з 50 копійок.
На банкнотах 100 та 500 гривень звичайно були мікроби, і багато, але патогенних не виявили.
Можна зробити різні припущення, чому так. Або гроші перед тим потрапили випадково в пральну машину, або надто нові, або 500 гривень не так часто зустрічаються в гаманцях вінничан, аби накопичити на собі різну гидоту. Чого не скажеш про дрібні купюри.
Хоча, за словами Олени Марцінковської, не можна говорити і про кишкову паличку, як про щось жахливе, адже це мікроорганізм, який присутній, і має бути присутнім у нас з вами.
- Сама кишкова паличка не викликає захворювання, вона як санітарно-показовий мікроорганізм, який свідчить про те, що тут можуть бути сальмонели, - говорить бактеріолог. - Але щоб заразитися сальмонелою, її потрібно підростити до критичної маси і потім з’їсти.
Тобто, хоч облизуйте купюру з кишковою паличкою, хоч жуйте цілу купу - заразитися сальмонелою не вийде. Те ж саме і про стафілокок. Щоб не захворіти, варто дотримуватися простих правил гігієни - мити руки. Після туалету, після транспорту, після прогулянки. Та після грошових розрахунків теж, про всяк випадок.
Олена Марцінковська, бактеріолог:
- Ви знаєте, що мікробів у нашому організмі в рази більше, ніж клітин, тобто не зрозуміло, хто в кому мешкає. Більш того - мікроби виконують захисну функцію для нашого організму, і всі проблеми зі здоров’ям виникають, коли слабкий імунітет. Насправді наш організм дуже розумний, він завжди знає, як, коли і де зреагувати. Знаєте, як колись до ери антибіотиків лікували людей?Є книжка академіка Кухотського, про те, що під час Першої світової пораненим вводили під шкіру їх власний гній з ран і таким чином рятували їм життя - це аутовакцина (вакцина з власних мікробів), якою стимулювали організм працювати і боротися. А ми почали з ними війну антибіотиками, у багатьох випадках непотрібну, і в результаті маємо більш сильні та стійкі мікроби.
Усі бояться кишкової палички, сальмонельозу, але для того, щоб ними заразитися, сальмонела має потрапити в їжу, і там розмножитися до критичної маси, а потім цю критичну масу потрібно з’їсти. Якщо ж немає механізму передачі - нічого страшного, ну живе собі сальмонела, хай живе в середовищі - ви ж не збираєтесь пити стічні води.Наприклад, часто сальмонельоз висівають у курей? Кури носять сальмонелу і не хворіють, для них це нормальна флора (до речі, людина теж може бути носієм і нічого). Якщо така курятина не пройшла достатньої термічної обробки, у 90% можна заразитися, хоча сальмонела гине через 5-6 секунд кип'ятіння, стафілококу потрібно більше - 30 хвилин.

Слідкуйте за новинами Вінниці у Telegram.
-
 Мальчиш ПлохишЦі руки нічого не крали .
Мальчиш ПлохишЦі руки нічого не крали .
-
 АнонімА кондиционеры которые их разтыривают еще небезпечніші...
АнонімА кондиционеры которые их разтыривают еще небезпечніші...